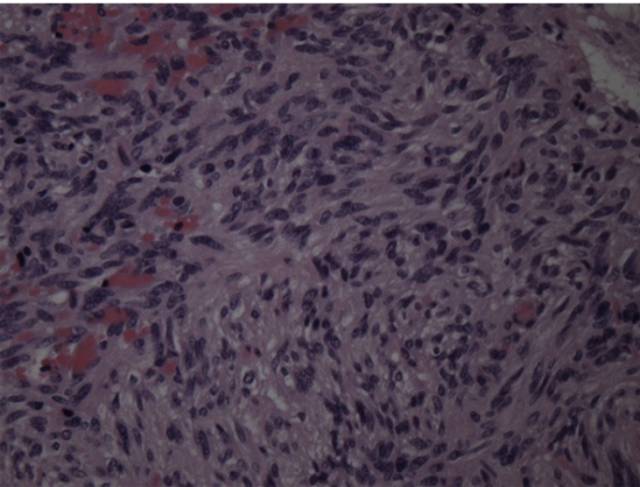
15种亚型脑膜瘤影像表现及诊断要点

15种亚型脑膜瘤影像表现及诊断要点
发布时间:2022-10-24
发布时间:2022-10-24
脑膜瘤病理分型及影像学特点
脑膜瘤形态多数为球形、分叶形,质地坚硬、血供丰富、包膜完整、分界清晰;少数为扁平、盘状,质地较软,沿脑表面蔓延,范围较广。
脑膜瘤血供:脑外脑膜瘤血供来自脑膜中动脉分支;脑室内肿瘤血供来自脉络膜动脉。肿瘤可出血、坏死,常有钙化。

好发部位:绝大多数发生在脑外。
常见于矢状窦旁、大脑凸面,大脑镰旁,其次蝶骨嵴、嗅沟、桥小脑角区、或鞍区,少数可位于脑室及脑实质内,单发或多发(2%)。

III 级:包括间变型(恶性)、乳头型和横纹肌样型,属恶性,约占10%。
病例1:



病例2:

TIWI C 显示病灶增强,呈囊、实性。MRS 病灶内波谱显示Cho峰明显升高,Cr、NAA峰无或甚低,出现GHS、Gly峰。虽肿瘤呈分叶状,但囊性区(体素4)不见Lip峰,提示为囊变而非坏死,且无明显瘤周浸润,故应诊断为良性囊性脑膜瘤。
病例3:


TIWI C 显示病灶呈实质性增强,FLAIR呈高信号,边缘见血管伸入。MRS 病灶内波谱显示Cho峰明显升高,无NAA峰, 出现GHS、Gly峰,并见到Lip峰。结合常规MRI所见,以及 Lip峰不高和瘤周(体素4)浸润不明显,提示含脂肪化生细胞较多的良性脑膜瘤可能为大,但恶性脑膜瘤不能除外。病理图片显示泡沫细胞,可能为出现Lip峰的原因。
病例一:

MR平扫病灶呈等高信号,TE=35ms,MRS波谱显示Cho、Glx、GSH、Gly峰升高,Cr峰降低,NAA峰消失,并见Ala峰;TE=144ms,显示Ala峰倒置。
病例二:


MR平扫病灶呈等信号,增强病灶呈较均匀强化;MRS病灶侧波谱显示Cho峰明显升高,Cr、NAA峰未显示,并见Glx、GSH峰和倒置的Ala峰。
病例一:男性,83岁,头痛



病理:混合型脑膜瘤

T1、T2显示鞍区实质性等信号肿块,垂体柄受压紧贴视交叉膈面。增强呈明显均匀强化,动态增强信号强度表现为早期快速升高,中后期缓慢下降。

HE染色示:过度型脑膜瘤(同时含有上皮型脑膜瘤和纤维性脑膜瘤的病理特点),可见椭圆形及细长形肿瘤细胞,细胞边界不清,胶质纤维较少。
3、病理组织基本成分由脑膜细胞、纤维母细胞、过度型细胞、血管、砂粒体组成。
病理结果:血管瘤型脑膜瘤


CT平扫(骨窗 脑窗)



病例:男性,30岁,头痛2月
CT平扫

MR平扫

MR增强

病理结果:富于淋巴浆细胞型脑膜瘤,WHO I级

2、CT密度较高,钙化少见。MR T1信号等或稍低、T2信号稍低或稍高,增强后呈明显强化;病灶内或边缘可见T1低信号、T2高信号区,增强后不强化;病灶边缘可见广泛增厚的脑膜强化。肿瘤界限模糊,似炎症,累及皮层,瘤周水肿明显(特征性表现)。
3、此亚型脑膜瘤有丰富的慢性炎细胞浸润,易伴发造血组织异常。病理上以上皮细胞增生伴大量淋巴细胞、浆细胞浸润为特点。
病例:女,37岁,头痛,精神错乱一年余。

病理结果:化生型脑膜瘤,内可见基质钙化和不规则骨小梁形成。

病例:

病例:

3、MRI :T2WI 呈稍高信号, T1WI 呈稍低信号, 明显增强而均匀强化; 部分病例可见明显的瘤周水肿。























上一篇:血管母细胞瘤诊断要点
下一篇:耳部—副神经节瘤